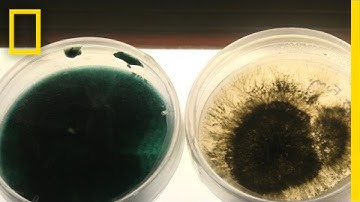
Oil-Eating Bacteria Could Be a Solution to Spill Cleanups | National Geographic

⬇ DOWNLOAD NOW
Kalau muncul iklan pop-up, tutup lalu klik tombol kembali
Download lagu 2019 Mechanical Engineering Capstone Project: Ocean Spray Fruit Firmness Study secara gratis hanya untuk keperluan promosi. Dukung artis favorit kamu dengan membeli musik original di iTunes atau platform resmi lainnya.
 Mechanical Engineering Capstone: Team Psych
Mechanical Engineering Capstone: Team Psych
 Mechanical Engineering Capstone Project
Mechanical Engineering Capstone Project
 Mechanical Engineering Capstone: Vehicle Lean Recovery System
Mechanical Engineering Capstone: Vehicle Lean Recovery System
 Bacterial nanosized speargun
Bacterial nanosized speargun
 🌊 Scientists Find Plastic-Eating Bacteria in the Ocean! 🧫
🌊 Scientists Find Plastic-Eating Bacteria in the Ocean! 🧫
Oil-Eating Bacteria Could Be a Solution to Spill Cleanups | National Geographic
Oil-Eating Bacteria Could Be a Solution to Spill Cleanups | National Geographic
 Bacteriën en antibiotica: de wraak van de microben
Bacteriën en antibiotica: de wraak van de microben
 How do soil microbes affect climate change?
How do soil microbes affect climate change?